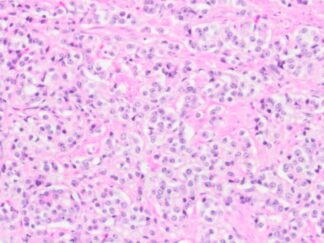

Human Prostate Cancer FFPE Sections
The human prostate cancer FFPE sections are mounted on positively charged glass slides and sectioned at 5 µm thickness. These FFPE slides can be used to perform RNA scope ISH, FISH IF, IHC and NGS, etc.
Showing all 3 results